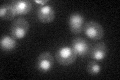
YDR513W
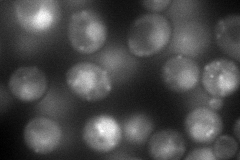
YDR513W
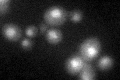
YDR513W

View description
Cytoplasmic glutaredoxin, thioltransferase, glutathione-dependent disulfide oxidoreductase involved in maintaining redox state of target proteins, also exhibits glutathione peroxidase activity, expression induced in response to stress
Localization:
Intensity:
Fold change:
Significance:
-
C’ GFP library in SD
nucleus33.84 -
N' NOP1pr-GFP in SD
punctate,nucleus131.435 -
N' TEF2pr-mCherry in SD

punctate,nucleus170.815 -
N' NATIVEpr-GFP in SD

nucleus34.6026 -
N' TEF2pr-VC and Cyto-VN in SD

below threshold24.151 -
C’ GFP library in SD+DTT
nucleus27.560.81No -
C’ GFP library in SD+H2O2

nucleus25.890.76No -
C’ GFP library in Starvation Media

nucleus18.720.55Yes -
C’ GFP library on the background of Pup2-DaMP

nucleus -
C’ GFP library on the background of CCT mutant

nucleus24.74240.730927No
